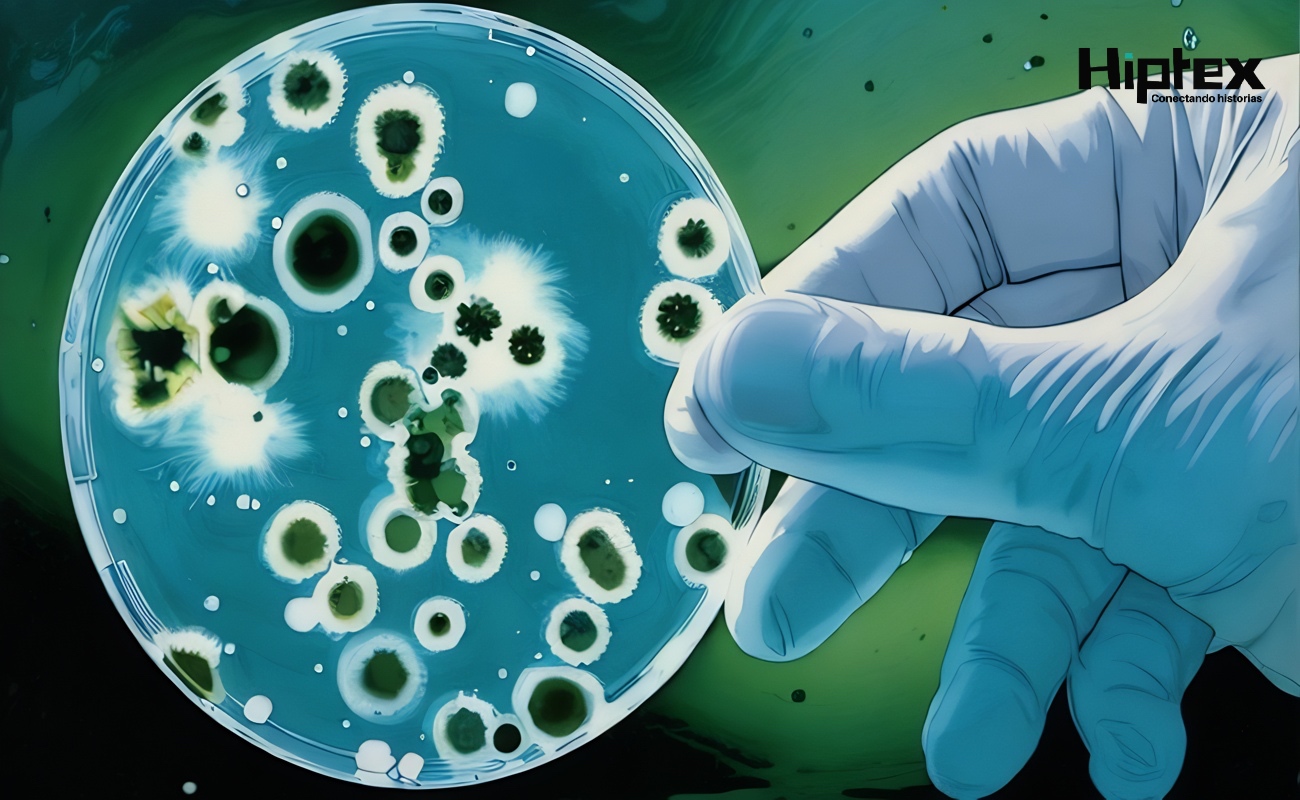
Tratan localizar evidencia genética de bacterias resistentes a medicamentos.

A Fondo
Expertos de la UNAM buscan en el río Querétaro bacterias resistentes a antibióticos
Se trata de una nueva etapa de la investigación que inició en 2001 “para dar seguimiento a aguas residuales urbanas” y evaluar, en tiempo real, “riesgos epidemiológicos”
Tratan localizar evidencia genética de bacterias resistentes a medicamentos.
Tratan localizar evidencia genética de bacterias resistentes a medicamentos.
CIUDAD DE MÉXICO.- Con el objetivo de localizar evidencia genética de bacterias resistentes a medicamentos, expertos del Instituto de Ingeniería (II) de la Universidad Nacional Autónoma de México (UNAM) analizan el agua del río Querétaro, ubicado en estado del mismo nombre, centro del país, indicó la institución.
En un comunicado emitido este sábado, el investigador del II, unidad académica Juriquilla, en Querétaro, Julián Carrillo Reyes, explicó que se trata de una nueva etapa de la investigación que inició en 2001 “para dar seguimiento a aguas residuales urbanas” y evaluar, en tiempo real, “riesgos epidemiológicos asociados a enfermedades infecciosas y a la resistencia antimicrobiana”, como herramienta complementaria a los sistemas clínicos tradicionales.
Durante su participación en la Reunión Informativa Anual (RIA) del II 2026 el también ingeniero ambiental precisó que su trabajo está relacionado con estudios secuenciales que muestran que “el drenaje puede actuar como un sensor comunitario sensible”.
Recordó que la primera prueba del monitoreo de 17 meses se realizó durante la pandemia de la Covid-19 y se enfocó en buscar residuos de SARS-CoV-2 en dos plantas de tratamiento, lo cual permitió anticipar olas epidémicas de la enfermedad hasta con dos semanas de antelación.
Carrillo Reyes, doctor en Ciencias Aplicadas, detalló que en 2023 y 2024, mediante técnicas metagenómicas (metaviroma) y RT-qPCR, detectó más de 20 virus humanos, incluyendo patógenos no reportados clínicamente como el de la viruela símica.
Agregó que, en colaboración con instituciones de Brasil, evaluó la presencia de siete genes de resistencia antimicrobiana, entre ellos Hepatitis A, Hepatitis B, Monkeypox, Influenza A y Papilomavirus en cinco plantas de tratamiento de ese país y de México, “revelando patrones de circulación consistentes con presiones antropogénicas”.
El experto indicó que, “si bien el monitoreo de agentes patógenos en aguas residuales está normado para determinar los promedios de su presencia, esto no ocurre en el caso de ríos”. Por ello, dijo, el trabajo propuesto por el equipo de la UNAM “permitirá demostrar su existencia y sentar las bases que lleven a crear una norma para su vigilancia”.
“Estamos efectuando muestreos mensuales en el río para ver qué sucede. Nos enfocamos en resistentes a antibióticos; efectuamos conteo de bacterias de patógenos y, posteriormente, se revisa cuáles tienen esa característica y, en términos sanitarios, son un riesgo inminente”, apuntó.
Adicionalmente, precisó, se revisa la presencia de aerosoles provenientes del agua, labor que se realiza en el laboratorio de ingeniería ambiental. Se correlaciona con la presencia de antibióticos en busca de contaminantes emergentes y cómo se vinculan con bacterias resistentes a antibióticos y otros patógenos.
TAGS
TE PUEDE INTERESAR












